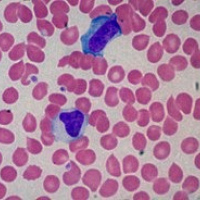
Anticuerpos heterofilos 906903  Idime. (2022)

Servicios de Salud Ofrecidos
Somos GM SALUD HUMANA. Nuestra sede principal está en la ciudad de Bogotá.
La forma más fácil de obtener nuestros servicios es escribiendo a nuestro WhatsApp 3167561793. Incluido el servicio de asesoría y consultoría en la Implementación y Desarrollo de Sistemas de Gestión en Seguridad y Salud en el Trabajo de las empresas, brindado en la ciudad de Bogotá.
Abajo debe usted encontrar el servicio médico que está buscando. Brindamos servicios en 31 ciudades a julio de 2023.
Nuestro director es el Dr. Germán Maldonado Morales, egresado de la Universidad Nacional. Usted puede verificar su idoneidad en la Página del Ministerio de Salud y Protección Social de Colombia:
https://web.sispro.gov.co/THS/Cliente/ConsultasPublicas/ConsultaPublicaDeTHxIdentificacion.aspx
Allí puede usted verificar su registro en el ReTHUS con su número de cédula : 19438233
BÚSQUEDA POR CIUDADES: